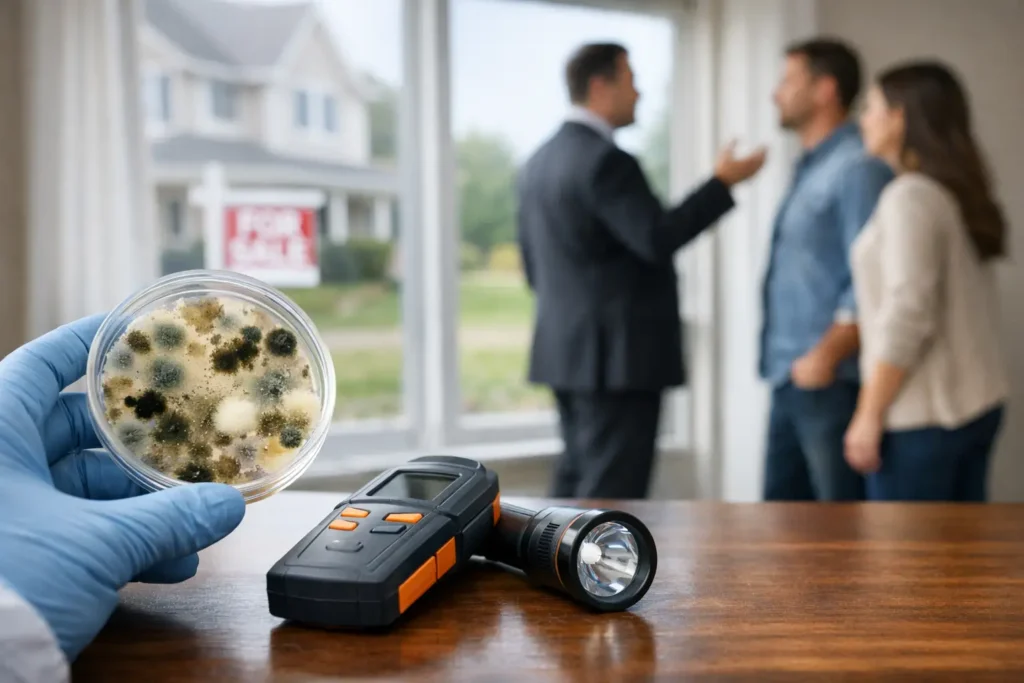
Mold Testing for Home Purchase: What Matters

Not all mold is dangerous! Don’t let other mold testing companies scare you.
Certified Mold Services
Mold Testing & Inspections
Mold Removal & Remediation Services
Mold Inspection, Testing & Removal
CALL NOW FOR SAME DAY MOLD INSPECTION & TESTING SERVICES
Testimonials
Certified Mold Testing & Inspections in the Tri-State Area Since 1995

Mold Removal & Remediation Projects
Certified Mold Removal Inc.
CALL NOW FOR SAME DAY MOLD INSPECTION & TESTING SERVICES
GET HELP NOW
"*" indicates required fields
THE SOURCE OF YOUR PROBLEM MUST BE FIXED BEFORE MOLD REMOVAL SERVICES CAN BEGIN
Before beginning any mold removal and remediation project we must first perform a detection and assessment of what mold issues have caused your need for abatement services.
Common sources of mold growth include plumbing leaks, improper ventilation, high humidity issues and water damage events. Whatever the source is, it is necessary to fix this first, before any mold removal and mold remediation in New Jersey, Pennsylvania, Connecticut and New York can take place.
During your initial detection and assessment services visit, your professional mold inspection and mold testing services specialist will search for the sources of your need for mold abatement services in your home or office. During this mold inspection, your certified mold inspector will need to take mold testing samples to learn if the physical contamination in your home has spread airborne or not.
Once the New Jersey mold testing laboratory evaluates the samples we will be able to use that information to create a professional written protocol for NJ mold removal and mold remediation services for your home or business.
UNDERSTANDING THE HEALTH AFFECTS OF AIRBORNE MOLD CONTAMINATION
Not all mold is dangerous! Don’t let other companies scare you and your family! This is why professional mold testing is a necessary first step in determining how severe your abatement problem is. It also gives us the necessary information so we can create an effective mold removal and remediation protocol for your home or office.
We, at Certified Mold Removal Inc. take the health of you and your family seriously which is why we always adhere to all EPA and IICRC S520 standards and guidelines for safe mold removal in your home or business.
Our certified mold inspection and testing specialists will always carefully explain all of the mold removal and mold remediation activities that need to take place during your mold abatement services project. Our primary job is to make certain that all physical contamination as well as the indoor air quality in your home or business is returned to normal once your mold removal and remediation project is completed.
One of our main goals is to keep you and your family safe during and after the mold removal process is complete. You can rest assured knowing that Certified Mold Removal Inc. has the professional assessment and detection experience to provide you with the most cost effective solution to the mold removal and remediation problems in your home or office.
LEAVE MOLD ABATEMENT SERVICES TO A PROFESSIONAL COMPANY
Effective mold removal and remediation services are quite complex and therefore better left to professional abatement specialists. Attempting to carry out the mold removal and remediation process by yourself or allowing a general contractor to do this for you can spell disaster! More often than not, improperly trained companies who try their hand at professional mold removal and abatement services will end up spreading the contamination airborne in your home or office, causing an even bigger mold infestation problem than the one you began with.
Many times the homeowner will become incur health problems as a result of improperly followed mold removal and remediation protocols. One example is not wearing the proper Personal Protective Equipment (PPE) when performing this work. Another issue is improper containment procedures which allows airborne mold contamination to spread to unaffected clean areas of the home. A mold removal and remediation can quickly get out of hand when these important procedures are not followed.
When you select a certified mold remediation company like Certified Mold Removal Inc. to perform a professional assessment and diagnosis of your home, you can rest assured that we will always keep you and your family safe during your certified mold inspection & remediation services project.

The team I had was awesome. They had the job done in half the time and it looks great. All aspects of the job were handled very professionally. All my questions were answered to completeness. Highly recommend.